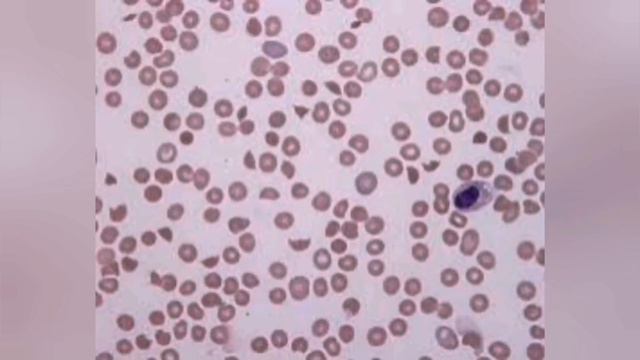
Escherichia coli смотреть онлайн

Автор: Mindful Minutes Страница 2

Играть не умею, но старательно делаю вид что умею

Этот видос о том как 2 гения играли в кс го.
Escherichia coli

Свитшот оверсайз "FB sister". Широкий балахон. Одежда по низким ценам.

Как стать гроссмейстером Вебинар

Капуста маринованная с овощами. Простой рецепт. Together Forever.

ВНИМАНИЕ ВЫ МОЖЕТЕ ОГЛОХНУТЬ ТАК ЧТО СМОТРЕТЬ НА СВОЙ СТРАХ И РИСК

Шныри в тюрьме,на зоне.

Я не знаю, что сказать

УЗНАТЬ ДРУГ ДРУГА БЛИЖЕ

Why you keep quitting online courses (and then buy more)

Распаковка Furby Connekt/Miss X

ПРОЩАЙ, КЛЕМ! | ЛУИСТИНУ В МАССЫ! | THE WALKING DEAD GAME: THE FINAL SEASON | TAKE US BACK

Обзор рынка форекс 15.07.2022

Приветик это моё первое видео простите за плохое качество

мувик - мне скучно жить💘😔

За что можно кинуть страйк на ютубе?

Дом Благодати: / Шлем спасения. / Проповедь Игоря Борисова.

Таро Гадание! Что Происходит за Вашей Спиной!

Я чувствую скоро Сэлу будет конец,Mafia III #11

Красивая музыка для души

МЫ РАССКАЖЕМ ВАМ ЧТО ТАКОЕ PRО-МARKЕTING

Improvisation #1 - Maxime Bazerque on Baritone Saxophone

Избавьтесь от апатии и депрессии, используя 3 проверенных метода
За каждым успешным каналом стоит личность, идея и сотни часов кропотливого труда. Если вы здесь, значит, автор «Mindful Minutes» уже сумел зацепить ваше внимание своим уникальным стилем или подачей. А мы на RUVIDEO позаботились о том, чтобы вы могли изучить весь архив его работ в максимально комфортных условиях — без лишней суеты и преград.
Почему за работами канала «Mindful Minutes» так интересно наблюдать? Всё просто: это честный контент, который находит отклик в сердцах зрителей. На нашем ресурсе вы можете смотреть онлайн все видео любимого автора бесплатно и в хорошем качестве. Нам важно, чтобы вы видели каждую деталь и слышали каждый нюанс, поэтому мы используем только стабильные плееры из открытых источников Rutube.
Следите за новинками канала, пересматривайте старые шедевры и открывайте для себя новые грани творчества «Mindful Minutes». Мы постоянно обновляем ленту, чтобы у вас под рукой всегда были самые свежие выпуски. Никаких сложных регистраций — только вы и творчество, которое вдохновляет. Приятного вам путешествия по миру авторского контента на RUVIDEO!
Видео взято из открытых источников Rutube. Если вы правообладатель, обратитесь к первоисточнику.